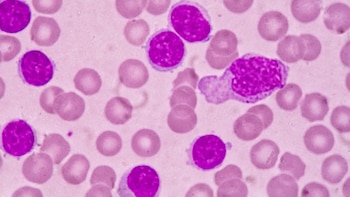
Los tratamientos cada vez van

"Enfermarse hoy de leucemia es muy diferente a haberlo hecho 15 años atrás. Para varios tipos de esta enfermedad estamos viviendo unos avances sin precedentes. Cada vez somos más optimistas, porque vemos que se sigue mejorando el pronóstico de estas complejas enfermedades oncohematológicas", sostuvo Fernando Piotrowski, director ejecutivo de la Asociación Leucemia Mieloide Argentina (Alma), y paciente con un tipo de leucemia.
La linfocítica crónica es el tipo de leucemia más frecuente en adultos, representa más del 30% de los casos. En el Congreso Europeo de Hematología (EHA), que tuvo lugar días atrás en Ámsterdam, se dieron a conocer resultados de una investigación que abre un nuevo capítulo en los avances contra esta enfermedad. Demostró que una combinación de medicamentos –libre de quimioterapia- permite obtener la remisión de la enfermedad en menos de un año. En otros países, esta combinación ya se puede indicar como "primera línea", es decir, que el profesional no debe esperar a que el paciente falle a otras terapias antes para indicar su administración.
"Los pacientes estamos todo el tiempo detrás de cada avance científico que nos permita controlar la enfermedad que tenemos, nos mejore la calidad de vida y el pronóstico. Sabemos que son condiciones complejas, pero afortunadamente, estamos en la era de los avances médicos constantes. Cada seis meses tenemos mejores noticias. Esperamos que este avance significativo que estamos conociendo sea una realidad para Argentina en el futuro cercano", agregó el director ejecutivo de Alma.
Todos los medicamentos tienen potenciales efectos adversos y es parte ineludible del tratamiento. De todos modos, los tratamientos cada vez van más dirigidos a donde se desencadena la enfermedad, impactando mínimamente en otras áreas o procesos del organismo.
"De hecho, para varias enfermedades oncológicas de la sangre, y la leucemia linfocítica crónica es un claro ejemplo, hay esquemas terapéuticos que ya no incluyen la quimioterapia. Entonces, muchas veces los pacientes pueden seguir con su vida normal, no interrumpir su trabajo, no verse disminuidos físicamente y evitar todas las complicaciones que la quimio origina por el riesgo aumentado de infecciones", subrayó Piotrowski.
La quimioterapia fue muy favorable en diversos tipos de cáncer y sigue siendo el tratamiento de elección en muchas ocasiones. Sin embargo, cada vez aparecen más opciones terapéuticas que evitan su indicación, lo que es muy valorado por los pacientes.
Tal como describió Piotrowski, "esta leucemia ya se define como crónica porque su avance es lento, a diferencia de las agudas, cuyo desarrollo es súbito. Hoy por hoy, además, en LLC se logró alcanzar la remisión completa, ya no se espera que avance, sino que se empieza a pensar en un futuro con un control total de la enfermedad, algo impensado sólo una década atrás".
Quienes conforman Alma acompañan día a día a los pacientes que presentan leucemias. Les brindan apoyo, contención y asesoramiento. Además, buscan llevar un mensaje esperanzador, porque en la actualidad el cáncer es una enfermedad a la que no hay que tenerle miedo, "no debe ser un tabú y tiene que empezar a poder hablarse del tema con naturalidad", sostienen.
"El cáncer o, en este caso, las enfermedades oncológicas de la sangre, no son sinónimo de muerte, todo lo contrario. Nadie elegiría de antemano tener que pasar por ellas, pero ofrecen una oportunidad para replantearse muchos aspectos de la propia vida, vivir mejor, valorar lo importante, mirar la vida con otros ojos y asumir el desafío de tener una actitud esperanzadora, más cuando hay muchas razones concretas para hacerlo", reconoció Piotrowski.

La leucemia linfocítica crónica presenta algunas particularidades. Un tercio de los pacientes nunca necesitará tratamiento. Otro tercio no necesitará tratamiento inmediatamente, pero deberá realizarse controles para ver en qué momento la enfermedad avanza y es necesario tratarla. El último tercio necesitará tratamiento tras el diagnóstico. Como no presenta síntomas específicos, en la mayoría de los casos, se detecta en forma incidental en chequeos de rutina.
"La importancia del diagnóstico radica en que el paciente esté controlado y, cuando lo necesite, reciba el tratamiento que su médico considere, y que sea el que mejores resultados le permita alcanzar", añadió Piotrowski.
Entre las principales preocupaciones que suelen manifestar los pacientes, se encuentran las dudas acerca de los efectos secundarios del tratamiento: si van a sufrir cambios corporales, cómo se van a sentir y si podrán mantener su vida normal. Esto grafica la importancia del desarrollo de nuevas terapias -libres de quimioterapia- que tienen un impacto mucho menor en la calidad de vida.
SEGUÍ LEYENDO
Últimas Noticias
Cuáles son los efectos de comer salchicha, jamón, chorizo y otros embutidos en personas que padecen hígado graso
Estos productos se consumen en diferentes presentaciones y horarios, ya sea en el desayuno, como ingrediente principal de guisos, en tacos, tortas o como botanas

La original entrada de María Becerra a los Premios Lo Nuestro junto a sus alter egos: “Con todas las chicas”
La cantante dio que hablar con su entrada junto a los personajes de su último álbum y lucir un vestido plateado que resaltó su estilo, marcando tendencia en la alfombra roja y mostrando su faceta más creativa

A qué hora juega San Martín vs Banco República: partido clave por fecha 3 del Sudamericano de Clubes de Vóley 2026
Tras enfrentar a Alianza Lima, las ‘santas’ se medirán con el cuadro uruguayo para definir su pase a las semifinales de la competición. Entérate de los horarios del crucial cotejo

Un gesto que no pasó desapercibido: así celebraron Ysabella Sánchez y Clarivett Yllescas el triunfo de Alianza Lima a San Martín
Tras el punto final, el festejo ‘blanquiazul’ tuvo una imagen que muchos vincularon con el técnico ‘santo’ Guilherme Schmitz, y que encendió las redes.

Suspenden operaciones en el Terminal Terrestre y Terrapuerto de Arequipa tras quedar inundados por intensas lluvias en la región
La repentina entrada de agua afectó a decenas de empresas y comercios dentro de los terminales, dejando a viajeros y trabajadores entre el lodo y la incertidumbre, sin certezas sobre cuándo podrán retomar sus traslados



